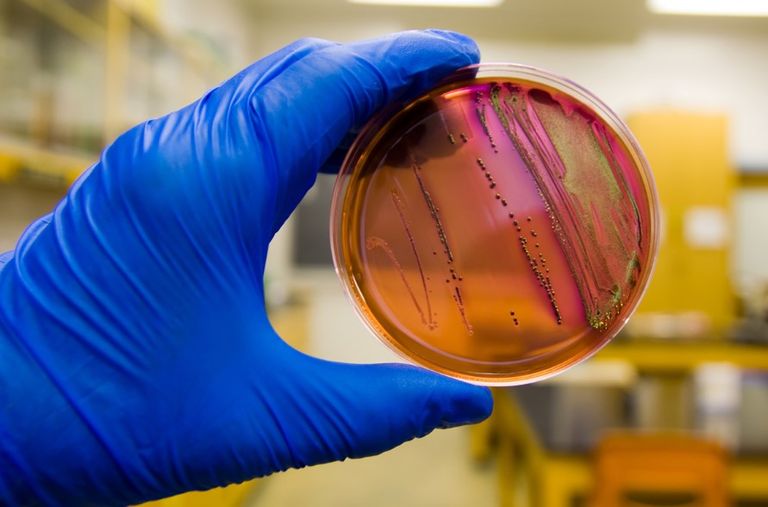
المياه الملوثة أحد مصادر الإصابة بالبكتيريا

بكتيريا الإيكولاي.. سر «الوباء الغامض» الذي أثار الرعب في مصر
أعلنت وزارة الصحة المصرية، الإثنين، أن ما وصِف إعلاميا بـ"الوباء الغامض" الذي ضرب مدينة أسوان منذ أيام وأثار الرعب في البلاد سببه بكتيريا الإيكولاي.
وقال الدكتور خالد عبدالغفار، نائب رئيس الوزراء ووزير الصحة المصري، إن الإصابة بالنزلات المعوية الحادة في أسوان يقف ورائها إصابة تلك الحالات ببكتيريا الإيكولاي.
وشرح: "الفحص الظاهري لعينات الإسهال يؤكد وجود عدوى بكتريا قولونية وتسمى (بكتيريا الإيكولاي)، وهي موجودة في أي مياه أو طعام ملوث"، مؤكدا أن "هذا ما أظهرته المعامل المركزية في القاهرة لنتائج تحليل عينات الإسهال والقيء أو المرضى المصابين".
ما هي عدوى بكتيريا الإيكولاي؟

بكتيريا الإيكولاي أو الإشريكية القولونية (E. coli) هي مجموعة من البكتيريا التي تعيش عادة في أمعاء الأشخاص الأصحاء، ووظيفتها المساعدة على هضم الطعام.
لكن في ظل ظروف معينة، يمكن للعديد من سلالات الإشريكية القولونية أن تجعل الشخص مريضًا بعدما تلتصق بالخلايا وتطلق السموم.
وشرح موقع clevelandclinic: "هناك سلالات ضارة من الإشريكية القولونية تسبب الإسهال المائي وآلام المعدة والتهاب المعدة والأمعاء إذا ابتلعتها عن طريق الخطأ".
وتسبب العديد من سلالات الإشريكية القولونية عدوى خفيفة، لكن بعض السلالات، مثل تلك التي تنتج سموم شيجا، يمكن أن تسبب أمراضًا خطيرة، بما في ذلك تلف الكلى.
وهناك حوالي 265000 حالة إصابة بالإشريكية القولونية المنتجة لسم شيجا (STEC) كل عام في الولايات المتحدة، إذ تعد السبب الأكثر شيوعًا لتفشي الإشريكية القولونية والمرض الخطير الناجم عن الإشريكية القولونية في أمريكا على سبيل المثال.
عادةً ما تظهر عليك أعراض الإصابة بعدوى الإشريكية القولونية في غضون 3 إلى 5 أيام بعد شرب أو تناول الأطعمة الملوثة بهذه البكتيريا الإشريكية القولونية.
يمكن أن تكون الإشريكية القولونية معدية أي تنتشر من شخص لآخر، وفي حين أنك لا تصاب بها من العطس أو السعال، يمكنك الإصابة بها من رعاية شخص مصاب بعدوى الإشريكية القولونية.
ما هي أعراض الإصابة بعدوى الإشريكية القولونية؟
تتضمن أعراض التهاب المعدة والأمعاء الناتج عن الإشريكية القولونية ما يلي:
الإسهال وغالبًا ما يكون مائيًا وأحيانًا دمويًا.
آلام وتقلصات في المعدة.
فقدان الشهية.
حمى منخفضة.
ألم في البطن أو الحوض.
ألم أو حرقان عند التبول.
حاجة ملحة للتبول بشكل متكرر.
بول غائم وكريه الرائحة.
ما هي أسباب الإصابة بعدوى بكتيريا الإيكولاي؟

يمكنك الإصابة ببكتيريا الإشريكية القولونية من خلال:
1. تناول الأطعمة الملوثة
يشمل ذلك اللحوم غير المطبوخة جيدًا والفواكه والخضروات النيئة التي لم يتم غسلها جيدًا.
2. شرب المشروبات غير المبسترة
يشمل ذلك الحليب أو عصير التفاح أو العصير(والأطعمة المصنوعة منها، مثل الجبن أو الآيس كريم.
3. شرب المياه الملوثة
يمكن أن تلوث الإشريكية القولونية الموجودة في براز الحيوانات والبشر مصادر المياه الطبيعية مثل البحيرات والجداول والأنهار وحمامات السباحة ومياه الشرب غير المعقمة.
4. لمس البراز أو الأسطح الملوثة
يمكن أن تنتقل البراز إلى يديك من تغيير الحفاضات، أو المسح بعد حركة الأمعاء، أو لمس الحيوانات الأليفة في حديقة الحيوانات أو المزرعة، أو مشاركة الأشياء أو الأسطح مع شخص مصاب بعدوى الإشريكية القولونية.
هل يمكن الوقاية من عدوى الإشريكية القولونية؟

بالتأكيد، يمكنك الوقاية من عدوى الإشريكية القولونية من خلال:
غسل يديك جيدًا قبل وبعد الطهي وبعد التعامل مع اللحوم النيئة أو الدواجن.
غسل يديك جيدًا بعد استخدام المرحاض أو تغيير الحفاضات أو ملامسة الحيوانات.
عدم تناول الحليب غير المبستر أو عصير التفاح.
غسل جميع الفواكه والخضروات النيئة تحت الماء الجاري قبل تناولها.
عدم إذابة اللحوم المجمدة غير المغلفة على المنضدة، والاحتفاظ بها في كيس بلاستيكي منفصل عند إذابتها.
عدم شطف اللحوم قبل الطهي، إذ قد يؤدي ذلك إلى انتشار البكتيريا إلى الأسطح والأواني والأطعمة الأخرى المجاورة.
استخدام لوح تقطيع بلاستيكي أو سيليكوني أو سيراميكي لتقطيع اللحوم النيئة.
طهي كل اللحوم على درجة حرارة آمنة قبل الأكل.
عدم وضع اللحوم المطبوخة على طبق كان عليه لحوم نيئة.
وضع بقايا الطعام في الثلاجة بعد الانتهاء من الأكل على الفور.